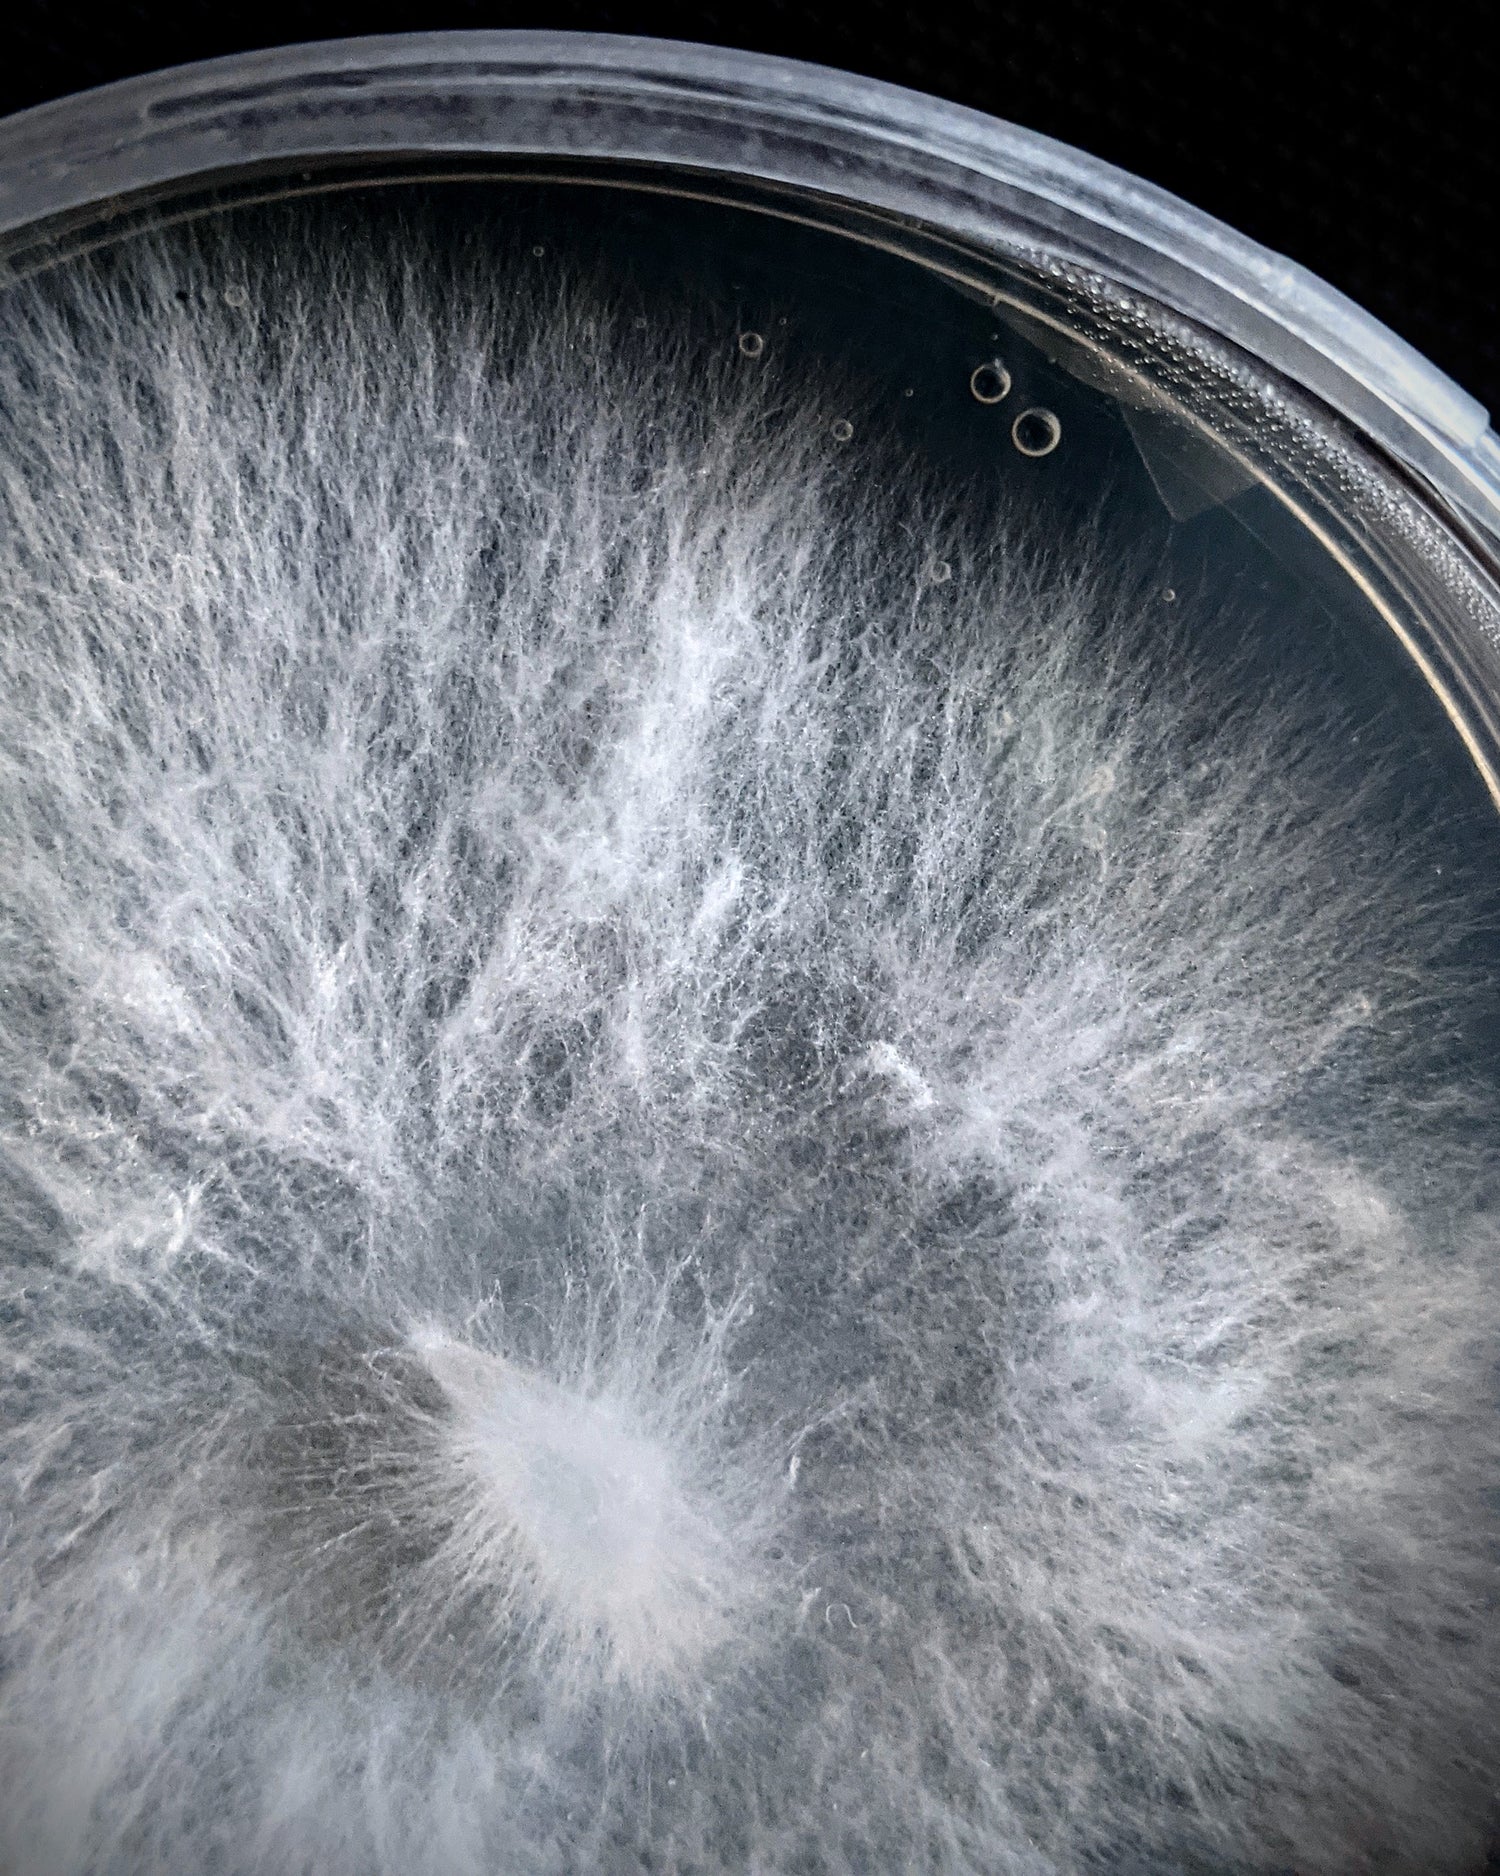

Cosa ci distingue?
-
Selezione
Il nostro studio ci porta ad una selezione di genetiche e specie di funghi particolari e rare, spesso mai viste sul mercato, dotate di alta qualità e di elevate caratteristiche culinarie.
-
Indipendenza
Controlliamo l’intero processo di coltivazione. Non ci affidiamo a nessun’altra azienda per ottenere parti del ciclo biologico del fungo. I funghi sono nostri dall’inizio alla fine, li facciamo germinare, colonizzare, espandere ed infine crescere. Gli forniamo noi i nutrienti migliori sul quale cibarsi durante ogni fase del loro ciclo biologico. Questo ci permette non solo di garantire un prodotto di altissima qualità, ma anche di lavorare su quelle caratteristiche del fungo piú desiderate.
-
Controllo
Controlliamo l’ambiente di crescita del fungo. I nostri funghi crescono in un ambiente controllato, dove forniamo le condizioni migliori per la loro crescita. Si evitano così insetti e patogeni tanto comuni quando coltivati all’aperto, in grotta, o quando si consumano funghi selvatici. Il fungo coltivato in questa maniera é a dir poco perfetto.
-
Freschezza
I funghi raccolti noi li consegnamo il giorno stesso! Non ci piace aspettare, ci piace dare ai nostri clienti un prodotto più fresco possibile. I nostri funghi vengono raccolti ogni mattina e consegnati al cliente poche ore dopo.

Il lavoro che c’é dietro
Ognuno dei nostri funghi raccolti percorre un viaggio simile…
La Nascita...
Le prime fasi di crescita avvengono su delle piccole piastrine da laboratorio. Qui i funghi cominciano ad esplorare e ad abituarsi ai nutrienti che gli forniamo. Piano piano imparano cosí a digerire quei composti che dovranno poi decomporre nella loro fase finale di crescita.

Il Viaggio
Man mano che maturano gli aiutiamo ad espandersi. Con i nostri strumenti ci trasformiamo in navi spaziali, e li facciamo viaggiare su nuovi substrati, che colonizzeranno. Diventano cosí una colonia in espansione ed esplorazione, viaggiando nello spazio e nel tempo, grazie al nostro aiuto.

L'Atterraggio
Nelle fasi finali di questo viaggio e di questa espansione, li portiamo sul loro pianeta finale: il substrato a base di legno, che colonizzeranno e del quale si ciberanno, fino alla loro piú spettacolare trasformazione.

...Morte e Rinascita
In questa fase finale della loro crescita, il fungo si trasforma formando strutture che in pochi giorni evolvono da piccoli spilli a grossi gambi e cappelli, dai colori e dalle forme più svariate. Il frutto del nostro duro lavoro e del duro lavoro di questo fungo, può finalmente essere raccolto!
Funghi Freschi
Produciamo varie specie di funghi gourmet e medicinali freschi per la vendita diretta a ristoranti. Abbiamo una produzione continua di 12 varietá di funghi di altissima qualitá. I funghi appena raccolti vengono consegnati solitamente il giorno stesso o al massimo il giorno seguente. Garantiamo una freschezza assoluta ed un prodotto mai visto prima sul mercato!
A Chef e ristoratori consigliamo di mettersi in contatto con noi per provare i nostri prodotti ed eventualmente stipulare un accordo per la fornitura regolare di funghi freschi. Sotto richiesta possiamo produrre regolarmente prodotto fresco da consegnare settimanalmente. Mettetevi in contatto con noi per il listino completo delle varietà di funghi da noi prodotte.
Leggi cosa distingue la nostra produzione da quella degli altri!
Preferiti dai migliori ristoranti della capitale!
- Glass Hostaria
- Bistrot 64
- Aromaticus
- Fase
- Retrobottega
- Bonci
- Enofficina
- Sbracio
- Roots
- Pizza Chef
- Aede
- Lievito Pizza Pane
- Forno di Veio